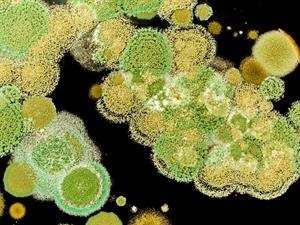
shutterstock_662171851.jpg

PUMPA - SMART LEARNING
எங்கள் ஆசிரியர்களுடன் 1-ஆன்-1 ஆலோசனை நேரத்தைப் பெறுங்கள். டாப்பர் ஆவதற்கு நாங்கள் பயிற்சி அளிப்போம்
Book Free Demoயூகேரியாட்டிக் செல் அமைப்புக் கொண்டவை
- பூஞ்சைகள், பெரும்பாலும் பல செல் உயிரிகள், ஆனால் சில ஒரு செல் வகை உயிரினங்களும் இவற்றில் அடங்கும்.
- பூஞ்சைகள் தம் வளர்ச்சிக்குத் தேவைப்படும் ஊட்டச்சத்துக்களை தனக்குத்தானே உணவுப்பொருட்களின் மீது படர்ந்து, அவற்றை நொதிகள் மூலம் செரித்து உறிஞ்சிக்கொள்கின்றன.
- மேலும், இவைகள் பிறசார்பு ஊட்டமுறையில் சாறுண்ணிகள், சிதைப்பான்கள், ஒட்டுண்ணிகள் போன்று வாழ்கின்றன.
Example:
மோல்டுகள், மில்டீயூஸ், நாய்க்குடைக்காளான்கள், ஈஸ்டுகள்

மோல்டுகள், ஈஸ்டு


மில்டீயூஸ், நாய்க்குடைக்காளான்